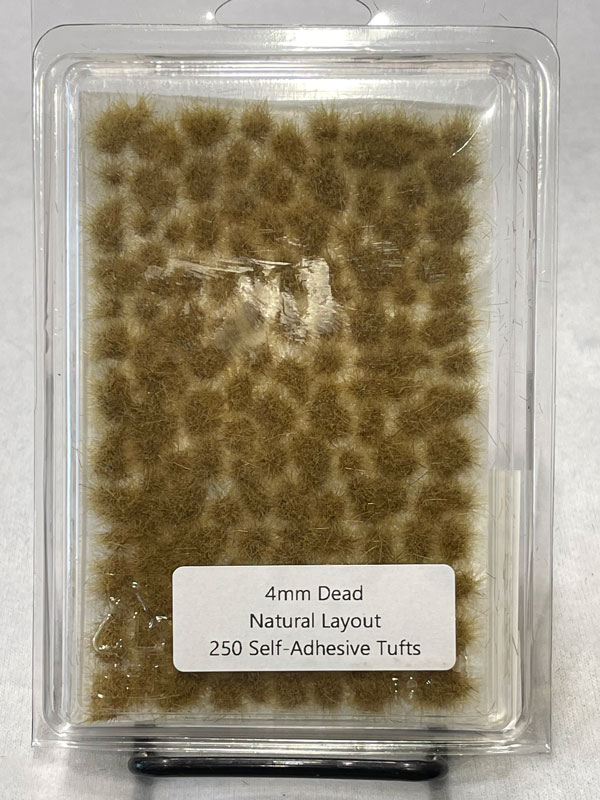
Shadows Edge 4mm Dead Tufts Natural Layout

Shadows Edge Miniatures

Shadow's Edge Miniatures is a hobby supply company based out of Northeast Georgia. Founded in 2016, Shadow's Edge Miniatures is a family company dedicated to quality, customer service, and support of the miniature gaming community.
What started as a passion for the miniature hobby grew into the dream of providing the best possible basing products for miniature wargamers, roleplaying creators, train and model ethusiests, board gamers, dollhouse lovers, and much more.
Zach makes some the finest tuffs we've ever seen (and we have seen a lot). Check out the ones with the rocky bits! And when they say Self Adhesive Tufts, they mean it. These babies really do stick! We are currently rolling out their range in stages as to not over whelm them with orders! More will be added here on a regular basis.